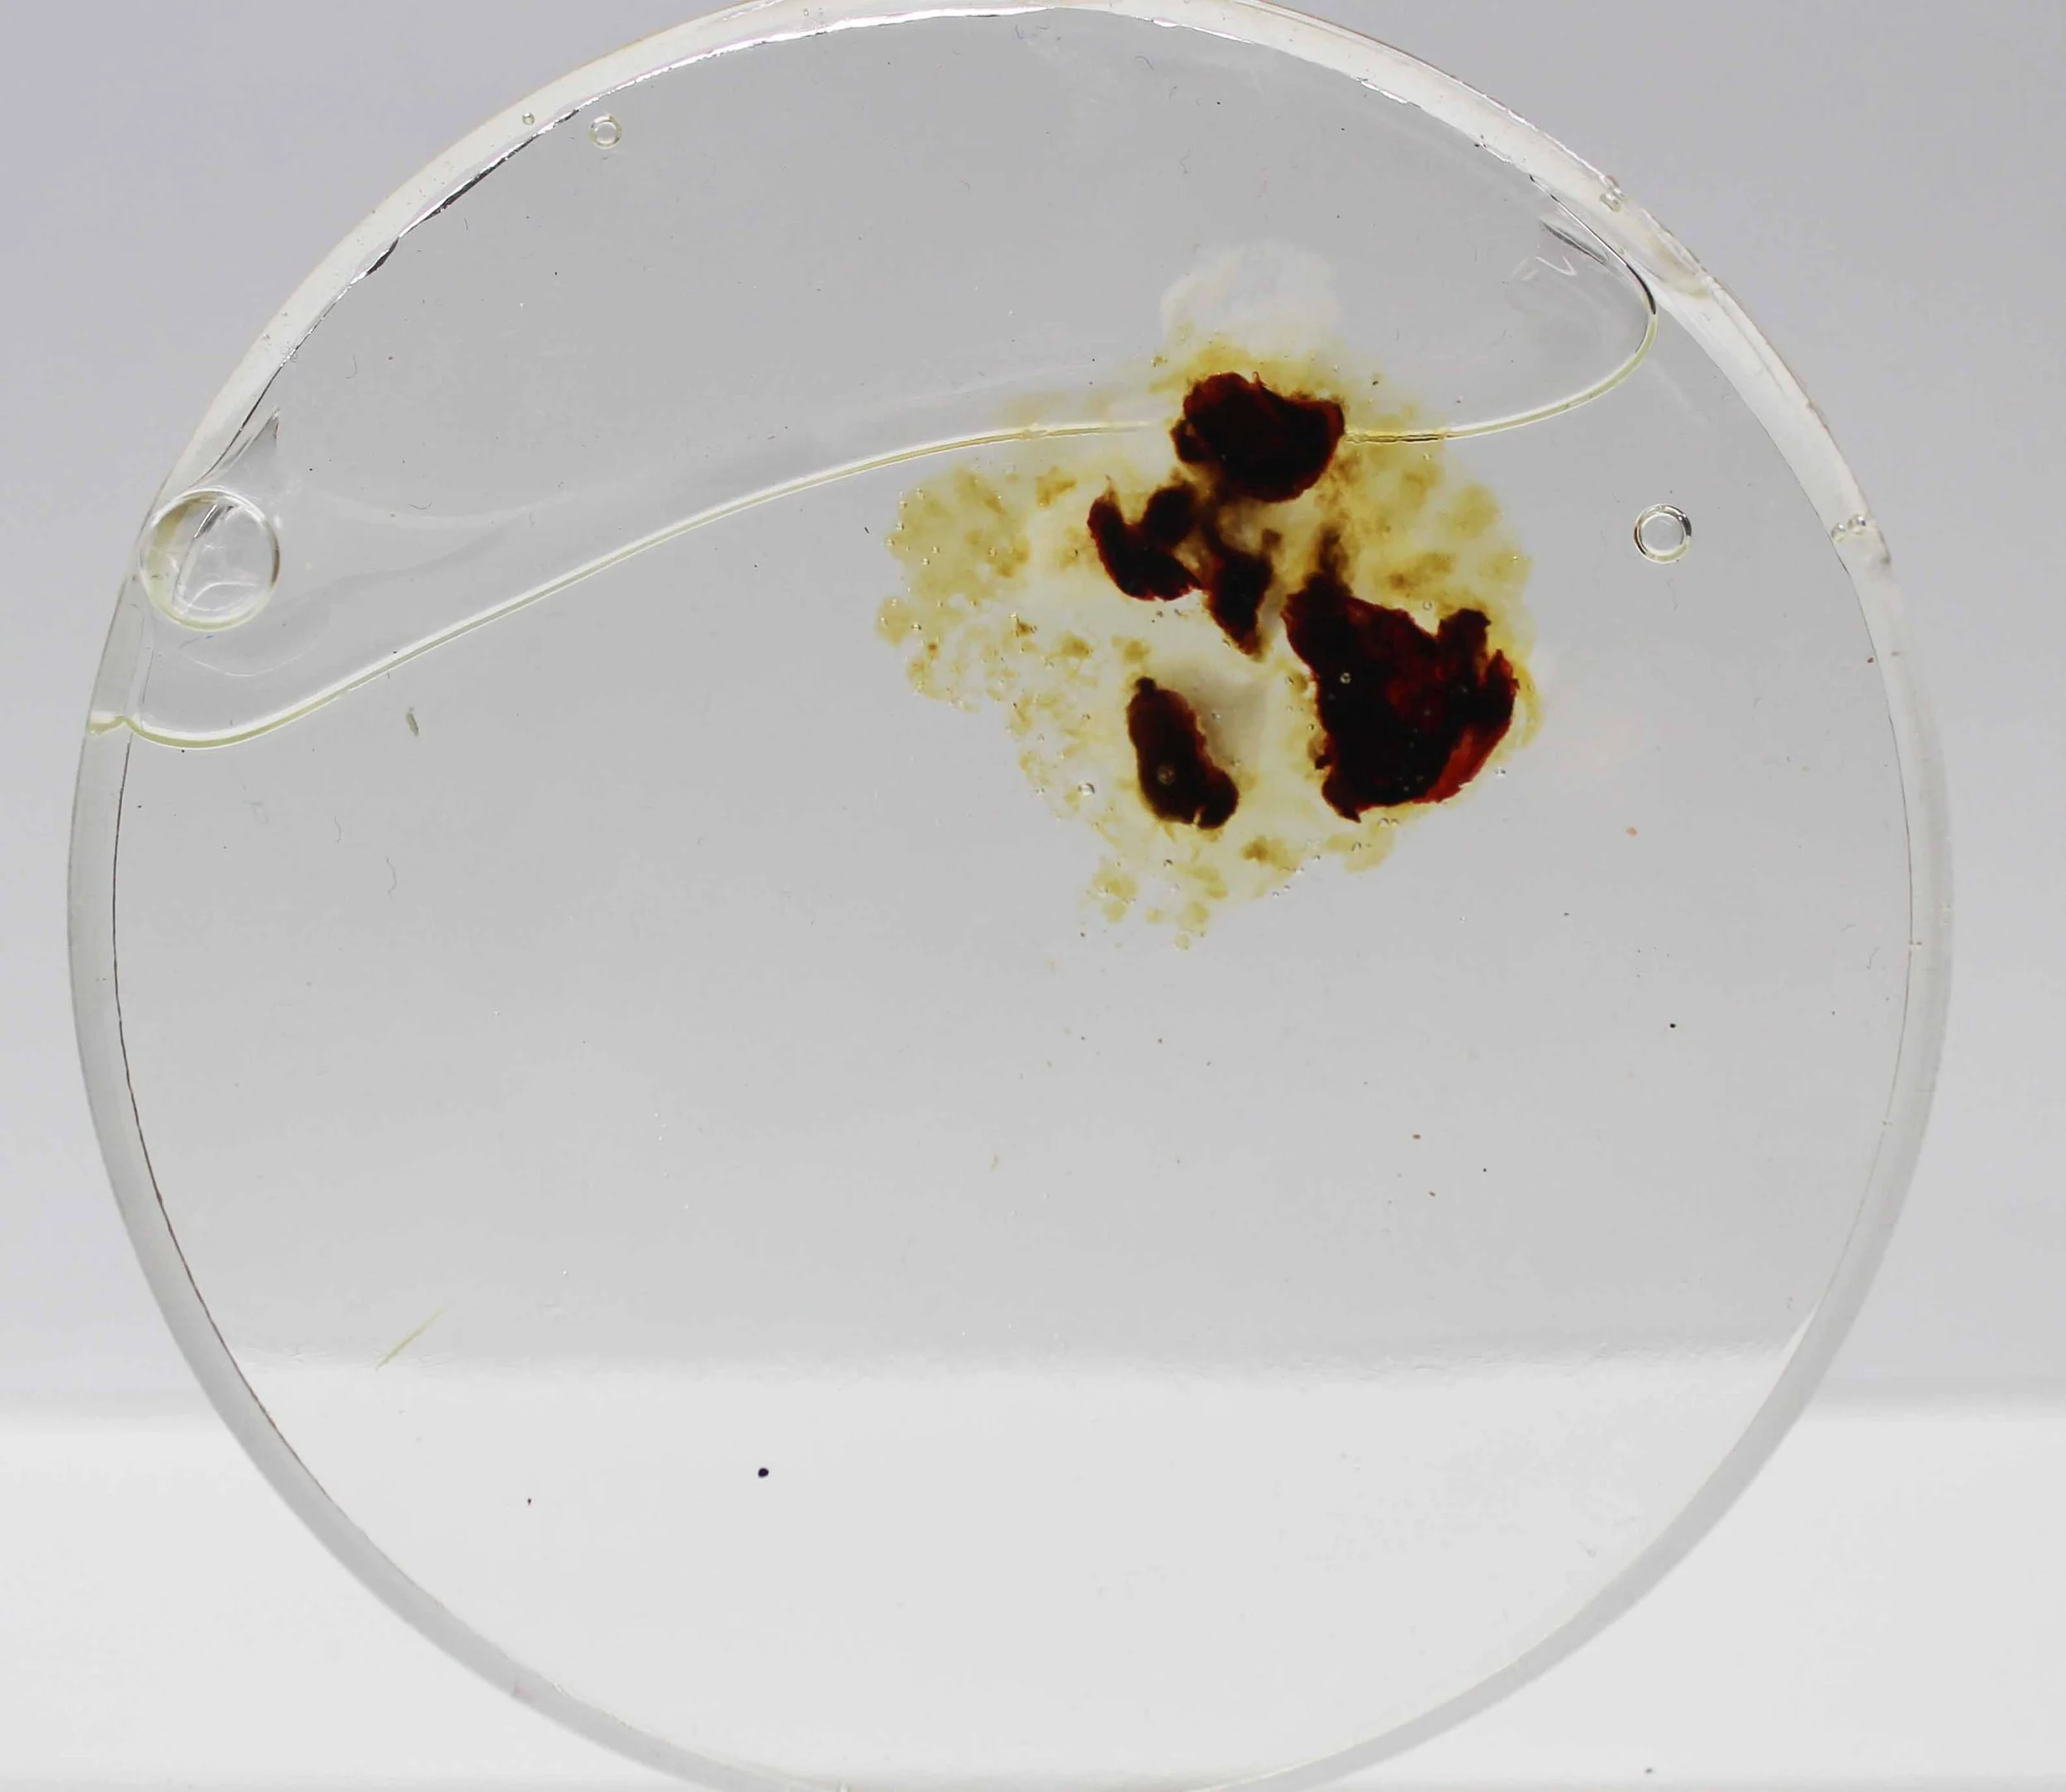

dysregulated series
2023 - 2024
Dysregulated is a series of resin discs preserving the artist's menstrual blood, collected over 12 monthly cycles. The work is displayed in chronological order; each disc is marked with the dates the blood was collected.
The collection serves as a documentation of the quantity and quality of menstrual blood the artist shed over one year. The intention of this work was to further the artist's understanding of her own menstrual cycle and create a collection of visual data to represent what an "average" cycle may look like while using the Implant as birth control.
Throughout the process, Jordan found that she had normalised the act of collecting her menstrual blood to the point of ritual; it became automatic to reach for the collection container rather than empty the blood into the toilet. Using her hands to examine the quality of the blood became an subconscious practice.
Although Jordan admits she is still disturbed by the blood at times, ultimately she has accepted the blood as an ordinary bodily substance and hopes that, upon viewing this work, others will do the same.
04 - 06 December 2024 Menstrual blood in resin
01 - 03 December 2024 Menstrual blood in resin
01 November 2024 Intermenstrual Blood in resin
31 October 2024 Intermenstrual blood in resin
30 October 2024 Intermenstrual blood in resin
21 October, 2024 Menstrual blood in resin
18 - 20 October, 2024 Menstrual blood in resin
18 - 19 September, 2024 Intermenstrual blood in resin
17 September, 2024 Intermenstrual blood in resin
06 - 08 September, 2024 Menstrual blood in resin
04 - 05 September, 2024 Menstrual blood in resin
05 - 07 August, 2024 Intermenstrual blood in resin
25 - 27 July, 2024 Menstrual blood in resin
22 - 24 July, 2024 Menstrual blood in resin
25 - 26 June, 2024 Intermenstrual blood in resin
23 - 24 June, 2024 Intermenstrual blood in resin
12 June 2024 Menstrual blood in resin
10 - 11 June 2024 Menstrual blood in resin
08 - 09 June 2024 Menstrual blood in resin
16 - 18 May, 2024 Intermenstrual blood in resin
05 - 06 May 2024 Menstrual blood in resin
02 - 05 May 2024 2/2 Menstrual blood in resin
02 - 05 May 2024 1/2 Menstrual blood in resin
17 - 20 march 2024 1/2 Menstrual blood in resin Resin cured strangely, creating white patches. There is no mold growth.
17 - 20 march 2024 2/2 Menstrual blood in resin Resin cured strangely, creating white patches. There is no mold growth.
16 - 18 February 2024 Menstrual blood in resin
12 - 16 February 2024 Menstrual blood in resin
14 - 17 January 2024 Intermenstrual blood in resin
02 - 06 January 2024 Menstrual blood in resin
20 August 2023 Menstrual blood in resin
19 August 2023 Menstrual blood in resin
09 August 2023 Menstrual blood in resin
08 August 2023 Menstrual blood in resin
07 August 2023 Menstrual blood in resin
06 August 2023 Menstrual blood in resin
05 August 2023 Menstrual blood in resin
04 August 2023 Menstrual blood in resin
11 June - 18 June 2/2 2023 Menstrual blood in resin
11 June - 18 June 1/2 2023 Menstrual blood in resin